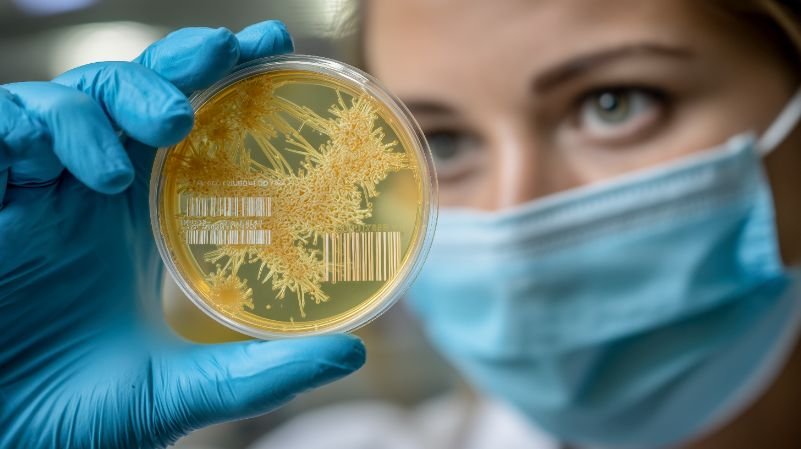

Vanguard Life Sciences enables emerging biotech, pharmaceutical and research ventures to accelerate innovation. Our rapid-deployment of self contained, mobile and modular cleanroom and containment suite facilities provide compliant, validated environments available at short notice, helping you move from concept to production with confidence.
We offer flexible procurement routes including rental, hire-purchase and Building-as-a-Service, and partnership, allowing you to preserve capital while scaling operations as your pipeline matures and navigate funding rounds.
As the enablers of innovation in Life Sciences, Vanguard encourage partnership opportunities and we are keen to work together to allow our partners to innovate so whether your challenges be time, financial or other we are here to help and work with you.
Vanguard Levenswetenschappen
Eenheid 1144 Regent Court, The Square, Gloucester Business Park, Gloucester, GL3 4AD
